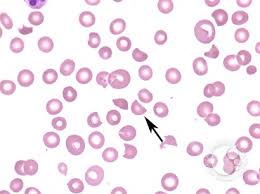
Weekend digest: name the most likely pathogen

- Presents with diarrhea
- Abdominal pain
- Renal failure

Image credit: ASH

Nene Nomo E. T.
@etnomo
Biomedical Scientist | Composer | Music Producer |
Opinions ≠ Medical Advice | My Views = My Own | Non Conformance
ID: 337587269
18-07-2011 08:03:47
829 Tweet
30 Followers
63 Following












Abstracts submissions are open for Early Career Summer Conference 2026. Hear from invited speakers and network with fellow early career members between 6—7 July. Registration opens 28 January: microb.io/ECConf26Abstra… #ECConf26 Uni of Birmingham